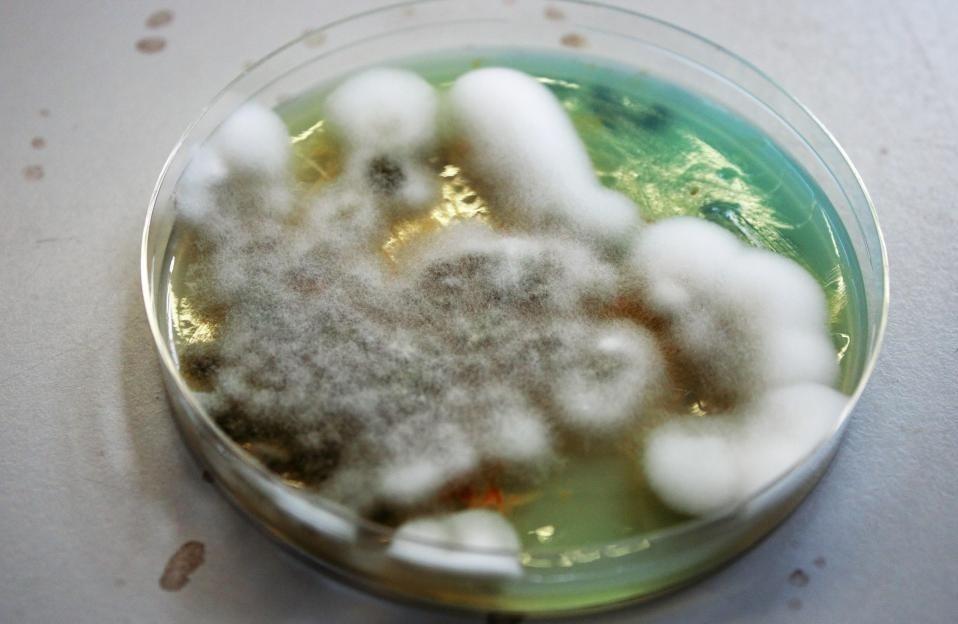

Nhóm nghiên cứu của Giáo sư Paul Matewele, Đại học London, Anh, phát hiện ra rằng 3/4 số tiền giấy và tiền xu bị nhiễm các loại vi khuẩn có thể gây bệnh viêm màng não, nhiễm trùng máu, hội chứng nhiễm độc cấp tính, sảy thai và ngộ độc thực phẩm.
Điều này khiến các chuyên gia kêu gọi bỏ lưu thông tiền mặt. Họ cho rằng việc này có lẽ là tốt nhất cho sức khỏe của người dân.
Các nhà nghiên cứu kiểm tra 3 mẫu thuộc mỗi mệnh giá tiền giấy và tiền xu đang lưu hành tại Vương quốc Anh. Họ phát hiện ra rằng 28/36 mẫu có dấu hiệu của 19 loại vi khuẩn khác nhau. Hai trong số đó là siêu khuẩn kháng lại kháng sinh mà Tổ chức Y tế Thế giới xem là mối đe dọa lớn. Một loại khác được tìm thấy trong phân người.
Trong năm qua tại Anh, khoảng 13,1 tỉ giao dịch tiền mặt được thực hiện, chiếm khoảng 22% tổng số giao dịch.
|
| Ba phần tư số tiền giấy và tiền xu đang lưu thông tại Anh bị nhiễm các loại vi khuẩn nguy hiểm. |
Giáo sư Paul Matewele cho biết số tiền mặt và tiền xu hiện lưu hành tại Anh là một hiểm họa đối với sức khỏe. Vì vậy, ông luôn cố gắng thanh toán bằng điện thoại hoặc thẻ khi có thể. Ông kêu gọi người dân cân nhắc bỏ lưu thông tiền mặt để góp phần giảm thiểu sự phát tán của những loại vi khuẩn này. Ông nói "Nếu một người mua bánh bằng tiền xu, họ nên rửa tay trước khi ăn".
Tụ cầu vàng kháng Methicillin là loại vi khuẩn có thể gây chết người. Nó được tìm thấy trên tiền xu mệnh giá 2 xu, 5 xu, 10 xu, 1 bảng, 2 bảng, và tiền giấy mệnh giá 10 bảng, 20 bảng, 50 bảng. Vi khuẩn kháng kháng sinh cũng có thể gây ngộ độc thực phẩm, viêm mô tế bào và hội chứng nhiễm độc cấp tính.
Vi khuẩn Listeria được tìm thấy trên tiền xu mệnh giá 20 xu, 50 xu, 1 bảng, và tiền giấy mệnh giá 10 bảng, 20 bảng. Vi khuẩn này có thể gây sảy thai và nhiễm trùng máu.
Một loại vi khuẩn khác là E. faecium. Loại này có thể gây viêm màng não ở trẻ sơ sinh, nhiễm trùng ruột, da, đường tiết niệu và máu. Nó được tìm thấy trên tiền xu mệnh giá 2 xu, 5 xu, 10 xu và tiền giấy mệnh giá 10 bảng.


